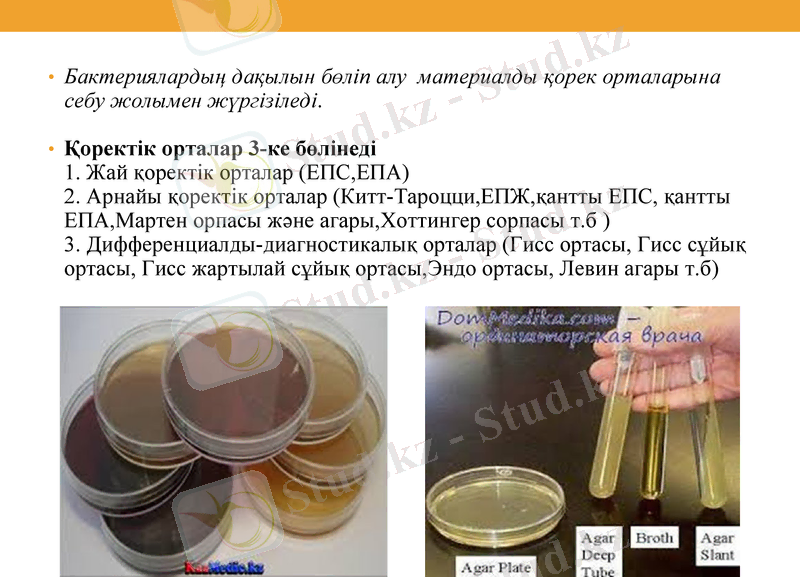
Slide 6
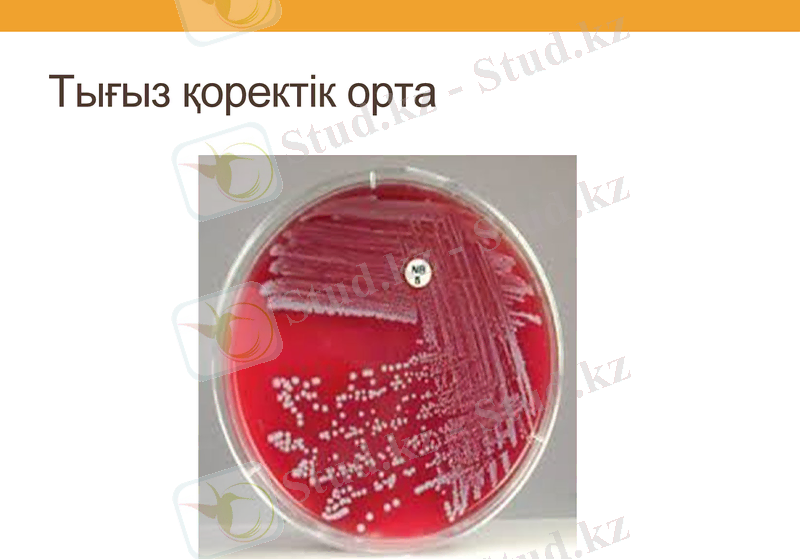
Slide 8

Бактериологиялық зерттеу нәтижелерін талдау және зертханалық диагностикалық әдістер



Қазақ ұлттық аграрлық университеті Ветеринария факультеті Микробиология, вирусология және иммунология кафедрасы
«Бактериологиялық зерттеу нәтижелерін талдау»
Орындаған: Еркебай Лаура
Бекбауов Еркебұлан Берікжан Бекзат
Тобы: ВМ-304
Қабылдаған: Көшкімбаев Серік

Сабақтың мақсаты: Бактериологиялық зерттеу нәтижелерін талдау
Жоспар:
1. Бактериоскопиялық тексеру
2. Микробтардың таза культурасын бөліп алу және олардың морфологиялық, өсінділік, биохимиялық, антигендік қасиеттерін тексеру
3. Зардаптылық қасиеттерін (биосынама) тексеру

Бактериоскопиялық тексеру
1. Жағынды даярлау. Препаратты дайындау техникасы қарапайым және келесі кезеңдерден тұрады. Сұйық дақылдан материалдың тамшысын заттық шыныға тамызады және ілмекпен жаяды. Тығыз ортадағы дақылдың аз бөлігін ілмекпен алады, физиологиялық ертіндімен араластырады және шыны бетіне жаяды. Жұғындыны даярлап болған соң ілмешекті спиртовка жалынына күйдіріп, залалсыздандырады.

2. Бекіту. Жағындыны ауада кептіреді, сосын оны бекітеді. Ең қарапайым және кең таралған әдіс - ыстықпен бекіту. Шынының жағынды жасалған бетін жоғары қаратып спирт шамынан үш рет өткізеді. Препарат күйіп қалмауы үшін бекіту уақыты 5 - 6 секунд болу керек, оттың тікелей әсер ету уақыты - 2 секунд. Бұл жағдайда жағынды шыныда жақсы ұсталады.

3. Бояу. Микробтарды бояу үшін ең бір қолайлысы анилин бояулары, соның ішініде оның ең негізгісі бейтарап түрі. Пфеффер фуксинімен жұғынды 1-2мин мерзімде ғана, ал метилен көгімен 3-5мин ішінде боялады. 4. Сумен шаю. Бояу мерзімі өткеннен соң бояудың артығын заттық әйнектен төгіп, сумен жуады.
Бактериялардың дақылын бөліп алу материалды қорек орталарына себу жолымен жүргізіледі.
Қоректік орталар 3-ке бөлінеді 1. Жай қоректік орталар (ЕПС, ЕПА) 2. Арнайы қоректік орталар (Китт-Тароцци, ЕПЖ, қантты ЕПС, қантты ЕПА, Мартен орпасы және агары, Хоттингер сорпасы т. б ) 3. Дифференциалды-диагностикалық орталар (Гисс ортасы, Гисс сұйық ортасы, Гисс жартылай сұйық ортасы, Эндо ортасы, Левин агары т. б)

Бактериологиялық табақшаларға тығыз қорек орталарына себу жасау орта бетіне материалдың бірнеше тамшысын шпательмен жағу арқылы жүргізіледі. Өлтірілген немесе өлген жануарлардың паренхиматозды мүшелерін зерттеу кезінде мүшенің кішкентай кесегін күйдіреді немесе фламбирлейді, сосын оларды стерильді қайшымен үстінен тіліп кеседі және пинцеттің көмегімен кесілген бетімен табақшадағы қорек ортасының бетінен жүргізеді. Сұйық ортаға материалды себу үшін пастер пипеткасын қолданады. Тығыз қорек ортасында микробтардың оқшауланған колонияларының өсуін алу үшін және зерттеу бактерияларын ілеспелі микроорганизмдерден айыру үшін Дригальский әдісімен бөлшектеп себу жүргізіледі. Себу жүргізілген табақшаларды және пробиркаларды бактериялардың әрбір түрінің өсуі үшін қолайлы температурада (жиі 37 °С), 1-2 тәулік, кейбір жағдайларда (туберкулез бактериялары) - 3 - 4 апта термостатта инкубациялайды.
Тығыз қоректік орта

Таза өсіндіні бөліп алу
Таза өсіндіні бөліп алу үшін микроптардың қоспасынан немесе басқа материалдардан ерітінділері дайындайды. Ол үшін натрий хлоридінің 0, 85%-дық ерітіндісі қолданылады. Дайындалған ерітінділердің үлгісін тығыз қоректік орталарға себеді. Ілмектің немесе пипетканың көмегімен Петри шынысындағы қоректік ортаға материалдың бір тамшысын тамызып, оны шпательмен таратады. Жекеленген микробтардың колонияларын алу үшін материалдың тамшысын бір шпательдің көмегімен бірнеше Петри шынысындағы қоректік орталардың бетіне таратады. Осылай кейінгі шыныларда жекеленген микробтардың мекендерін бөліп алуға болады. Шпательді шыны таяшалардан жасайды. Олардың бір ұшы үш бұрышты болып келеді. Петри шыны аяғының қақпағы себу кезінде жалын бағытында ашылады. Себуді аяқтағаннан соң шпатель күйдіріліп, штативке қойылады. Петри шынысы термостатқа аударылып қойылады. Аударылып қойылған шыныларда микробтардың колониялары бір-бірімен қосылмай өседі.

Бактериялардың антибиотиктерге сезімталдығын дисктер әдісімен анықтау.
Зерттелетін бактерия дақылын Петри табақшасынадағы қорек ортасына газонмен себеді, содан кейін оның бетіне пинцетпен біркелкі арақашықтықта әртүрлі антибиотиктердің белгілі дозасы бар қағаз дискілерін орналастырады (43 сурет) . Себулерді 37°С келесі күнге дейін инкубирлейді. Стафилококк дақылының өсу тежелу аймағының диаметрі бойынша оның сәйкес антибиотиктерге сезімталдығы туралы айтады. Өсудің тежелу аймағының диаметрі 10 мм дейін болғанда дақыл аз сезімтал, ал 10 мм жоғары болса - өте сезімтал деп бағаланады. Егер қағаз дискілерге бір антибиотиктің әртүрлі концентрациялары сіңірілген болса, зерттелетін бактерия дақылы сезімтал препараттың ең аз дозасын анықтауға болады.

Бактериялардың сахаролиттік қасиеттері
Бактериялардың сахаролиттік қасиеттерін оларды әр түрлі көмірсулары мен индикаторы бар дифференциалды диагностикалық орталарға себу арқылы анықтайды. Осы мақсатта Гисса ортасы жиі қолданылады. Әр түрлі көмірсулары бар орталардың жиынтығы (глюкоза, лактоза, мальтоза, сахароза, дульцит, арабиноза, сорбит және т. б. ), майсыздандырылған стерильді сүт, лакмусты сүт, метилен көгі бар сүт - «түрлі-түсті қатар» деп аталады. Микроорганизмдердің өсінділерін бактериологиялық ілмектің немесе Пастер пипеткасының көмегімен аталмыш қоректік орталарға себеді. Қоректік орталарды белгілі бір уақыт аралығында термостатта ұстағаннан кейін ферментациялану (өзгеріске ұшырау) деңгейін анықтайды: қоректік орта түсінің өзгеруі (Андредэ индикаторы болғанда қызыл түске өзгереді) көмірсулардың ыдырауы мен қоректік ортада қышқыл өнімдерінің түзілуінің дәлелі болып табылады.

АГГЛЮТИНАЦИЯ РЕАКЦИЯСЫ
- Іс жүргізу
- Автоматтандыру, Техника
- Алғашқы әскери дайындық
- Астрономия
- Ауыл шаруашылығы
- Банк ісі
- Бизнесті бағалау
- Биология
- Бухгалтерлік іс
- Валеология
- Ветеринария
- География
- Геология, Геофизика, Геодезия
- Дін
- Ет, сүт, шарап өнімдері
- Жалпы тарих
- Жер кадастрі, Жылжымайтын мүлік
- Журналистика
- Информатика
- Кеден ісі
- Маркетинг
- Математика, Геометрия
- Медицина
- Мемлекеттік басқару
- Менеджмент
- Мұнай, Газ
- Мұрағат ісі
- Мәдениеттану
- ОБЖ (Основы безопасности жизнедеятельности)
- Педагогика
- Полиграфия
- Психология
- Салық
- Саясаттану
- Сақтандыру
- Сертификаттау, стандарттау
- Социология, Демография
- Спорт
- Статистика
- Тілтану, Филология
- Тарихи тұлғалар
- Тау-кен ісі
- Транспорт
- Туризм
- Физика
- Философия
- Халықаралық қатынастар
- Химия
- Экология, Қоршаған ортаны қорғау
- Экономика
- Экономикалық география
- Электротехника
- Қазақстан тарихы
- Қаржы
- Құрылыс
- Құқық, Криминалистика
- Әдебиет
- Өнер, музыка
- Өнеркәсіп, Өндіріс
Қазақ тілінде жазылған рефераттар, курстық жұмыстар, дипломдық жұмыстар бойынша біздің қор #1 болып табылады.



Ақпарат
Қосымша
Email: info@stud.kz